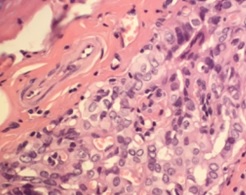
cover_article_857_en_US

-
The Mayo Clinic series includes:
-
900 patients with an average follow-up of 17.2 years (range of 6 to 89 years):
-
23% of the tumors were multifocal.
-
17% bilateral.
-
2% extrathyroidal.
-
30% had nodal involvement.
-
0.3% had distant metastatic disease.
-
-
Less than 25% were under 5 mm and over a third were 9 to 10 mm.
-
The 40-year cause specific mortalitywas 0.7:
-
All three patients who died presented with lymphadenopathy.
-
One had massive lymphadenopathy
-
One had pulmonary metastases upon presentation.
-
-
Recurrences occurred in 8% of patients:
-
Most in the cervical lymph nodes, but 1.5% occurred in the thyroid bed.
-
Nodal recurrences occurred in 16% of patients with positive nodes at presentation and only 0.8% of patients without nodes at presentation.
-
Recurrences occurred in 11% of patients with multifocal disease and 4% of patients with unifocal disease.
-
-
-
The Noguchi Thyroid Clinic in Japan series:
-
Included 2070 patients with an average follow-up of 15 years.
-
Recurrences occurred in 3.5% of patients at a mean of 10.3 years.
-
Distant metastases occurred in only 0.2% of patients.
-
Recurrence was more likely in patients with larger tumors (greater than 5 mm), more lymph nodes, and invasion (e.g., into the recurrent laryngeal nerve or esophagus), and less likely in patients with coexistent thyroid autoimmunity.
-
-
The series of 281 patients from the Gustave-Roussy Institute in France includes some patients with sub centimeter follicular thyroid cancers but demonstrates similar rates of recurrence:
-
2.5% in cervical lymph nodes.
-
1.4% in the thyroid bed.
-
-
The series of 203 patients from the Queen Elizabeth Hospital in Hong Kong reports a 4.9% rate of nodal recurrence and a 1% rate of local recurrences:
-
Two patients developed pulmonary metastases (1%), and two patients died.
-
The risk of lymph nodal recurrence was increased 6.2-fold when nodes were present at presentation and 5.6-fold when the tumor was multifocal.
-
The researchers did not find higher recurrencerates in tumors greater than 5 mm, but the larger micropapillary cancers were more likely to have extrathyroidal extension.
-
-
Recurrence occurred in 4.8% of 293 patients reported from South Korea after a median follow-up of 65 months:
-
Cervical nodes at presentation were associated with an increased risk of recurrence.
-
-
Recurrence occurred in 3.1% of 287 patients from Rome, Italy, and included 2 patients (0.7%) with distant metastases; multifocal disease, extrathyroidal extension, and a higher number of cervical nodes at presentation were risk factors for recurrence.
-
Data from several series show:
-
Multifocality in 20% to 40% of patients.
-
Bilateral disease in 10% to 19% of patients.
-
Extra thyroidal invasion in 2% to 38% of patients,.
-
Cervical nodal involvement in 17% to 43% of patients:
-
Distant metastases in 0% to 3% of patients.
-
-
In one series of 671 patients from Seoul, Korea:
-
24% had central nodal involvement.
-
3.7% had lateral nodal involvement.
-

Rodrigo Arrangoiz MS, MD, FACS a head and neck surgeon and is a member of Sociedad Quirúrgica S.C at the America British Cowdray Medical Center in Mexico City:
-
He is an expert in the management of thyroid cancer.
Training:
• General surgery:
• Michigan State University:
• 2004 al 2010
• Surgical Oncology / Head and Neck Surgery / Endocrine Surgery:
• Fox Chase Cancer Center (Filadelfia):
• 2010 al 2012
• Masters in Science (Clinical research for health professionals):
• Drexel University (Filadelfia):
• 2010 al 2012
• Surgical Oncology / Head and Neck Surgery / Endocrine Surgery:
• IFHNOS / Memorial Sloan Kettering Cancer Center:
• 2014 al 2016
http://www.cirugiatiroides.com
#Arrangoiz #HeadandNeckSurgery #EndocrineSurgery #SurgicalOncology #ThyroidSurgery #ThyroidCancerExpert #CirugiadeTumoresdeCabezayCuello #CirugiaEndocrina #CirugiadeTiroides #ExpertoenCancerdeTiroides #CancerSurgeon




